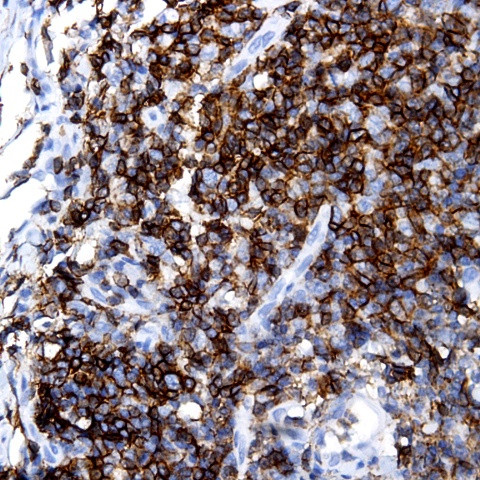
Lambda Light chain Antibody in Immunohistochemistry (Paraffin) (IHC (P))

Search
AbboMax
Lambda Light chain Polyclonal Antibody
{{$productOrderCtrl.translations['antibody.pdp.commerceCard.promotion.promotions']}}
{{$productOrderCtrl.translations['antibody.pdp.commerceCard.promotion.viewpromo']}}
{{$productOrderCtrl.translations['antibody.pdp.commerceCard.promotion.promocode']}}: {{promo.promoCode}} {{promo.promoTitle}} {{promo.promoDescription}}. {{$productOrderCtrl.translations['antibody.pdp.commerceCard.promotion.learnmore']}}
图: 1 / 1
Lambda Light chain Antibody (500-1884) in IHC (P)

产品信息
500-1884
种属反应
宿主/亚型
分类
类型
抗原
偶联物
形式
浓度
规格
纯化类型
保存液
内含物
保存条件
运输条件
产品详细信息
Positive control: Tosil
Cellular location: Cytoplasmic.
靶标信息
Immunoglobulin classes share the same basic four polypeptide chain structure of two heavy chains (five types) and two light chains (kappa, lambda; both having a molecular weight of 22.5 kDa). Kappa and lambda consist of a variable region and a constant region and can easily be differentiated by the antigenic properties of the constant region. The ratio of kappa to lambda is 70:30. Antibodies to the kappa light chain are reportedly useful in the identification of leukemias, plasmacytomas, and certain non-Hodgkin's lymphomas. Demonstration of clonality in lymphoid infiltrates indicates that the infiltrate is clonal and therefore malignant.
仅用于科研。不用于诊断过程。未经明确授权不得转售。
篇参考文献 (0)
生物信息学
蛋白别名: Bence Jones Protein; BJP; IGL; IGLC 1/2/3; Immunoglobulin L; immunoglobulin lambda light chain; Lambda LC; Mcg Marker; Paraprotein
基因别名: IGLC; IGLV
Entrez Gene ID: (Human) 3537, (Human) 3546